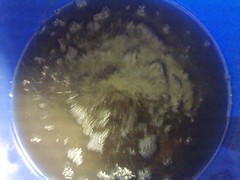
9541942090_50d9676e7e_m.jpg

-
We are officially moved over to Discourse.
Autoflower Discourse"
You will have to create a new login for the new site!
This current Xenforo-based forum will be preserved as a read-only archive going forward with efforts to better categorize and tag original and canonical content.
The URL autoflower.org will soon point to the new Discourse site; so we'll be back to business in a few days!
Send Son of Hobbes a private message if you have any questions!
You are using an out of date browser. It may not display this or other websites correctly.
You should upgrade or use an alternative browser.
You should upgrade or use an alternative browser.
Grow Mediums Mr and Mrs AutoOtto's medical cannabis Autoflower grow diary
- Thread starter AutoOtto
- Start date
Roark
Knight of the Scrog
- Joined
- Feb 23, 2013
- Messages
- 3,961
- Reputation
- 0
- Reaction score
- 10,712
- Points
- 0
- Currently Smoking
- Repel white widow and sour straws
Finally a moment to sit down and read up on your posts. Pictures of those girls rock. As for trimming, like alan said, maybe a scrogg. If not lolipopum. I have enjoyed taking the tops and letting the smaller buds fill in a bit more. Some of my girls are two feet above my scrogg. So that works for me. They had a very late growth spurt. Whatever you chose I am sure they'll do great. If it were me I would space the buckets out as far as possible when the canapy fills out.
Hope all is well.
Hope all is well.
7/18/13: I can totally identify with the first sentence of your post, Roark. Finally a moment to sit down and make another post. It's been over a week since our last post, just been too busy. Helping some friends with a collective garden do some trimming, great practice for these ladies coming up, heh, heh...
So right before this trimming work came up, our plants started to develop brown root algae, starting as a clear snot like substance growing on the roots, I read that cleaning all your lines and stones and doing a fresh bucket change, along with spraying off your roots can sometimes clear it up, so I tried this first, and for one day it seemed to be working, but just a couple days later the stuff was back, worse than ever, and finally
progressing to this:



Fortunately since I'm a member of a great forum such as this one, I had only to look to the posts of others who had dealt with the same problem. The DIY compost tea thread was fabulously helpful, although I did end up deciding to buy an all in one compost tea in a box. It was $49 for a supply that will make 40 gallons (enough to supply us for several grows) I had to brew the tea overnight:

while I went to help out my friends at the collective, then apply it, and go out to my friends from Friday night through Sunday morning. Needless to say, I was more than a little nervous leaving our babies for this long. My wife was here, but she doesn't yet know all the ins and outs of the garden, and with the brown algae the buckets ph has been jumping 2.5 to 3 full points in a matter of hours, but I sucked it up, ph'd the buckets, and left. Unlike me, you don't have to wait, here are the results:



I can't sing the praises of that compost tea enough! If anyone runs into this difficulty, I highly recommend it. Not only did the roots do a great job of healing up, but over a 2 day period, I didn't have to re-ph one bucket, every one fell comfortably in the proper ph range and some even stayed exactly where I had left them!! Wow!! The girls were starting to look a wee sad before, but now they're perking right up.

Another hurdle surmounted, and I don't believe we'll suffer from this issue any more. The NL's are finally starting to flower, when they get a little farther along more pics. Thanks to all out there following this thread, and looking forward to its successful conclusion.
:stylez rasta smoke:
So right before this trimming work came up, our plants started to develop brown root algae, starting as a clear snot like substance growing on the roots, I read that cleaning all your lines and stones and doing a fresh bucket change, along with spraying off your roots can sometimes clear it up, so I tried this first, and for one day it seemed to be working, but just a couple days later the stuff was back, worse than ever, and finally
progressing to this:



Fortunately since I'm a member of a great forum such as this one, I had only to look to the posts of others who had dealt with the same problem. The DIY compost tea thread was fabulously helpful, although I did end up deciding to buy an all in one compost tea in a box. It was $49 for a supply that will make 40 gallons (enough to supply us for several grows) I had to brew the tea overnight:

while I went to help out my friends at the collective, then apply it, and go out to my friends from Friday night through Sunday morning. Needless to say, I was more than a little nervous leaving our babies for this long. My wife was here, but she doesn't yet know all the ins and outs of the garden, and with the brown algae the buckets ph has been jumping 2.5 to 3 full points in a matter of hours, but I sucked it up, ph'd the buckets, and left. Unlike me, you don't have to wait, here are the results:



I can't sing the praises of that compost tea enough! If anyone runs into this difficulty, I highly recommend it. Not only did the roots do a great job of healing up, but over a 2 day period, I didn't have to re-ph one bucket, every one fell comfortably in the proper ph range and some even stayed exactly where I had left them!! Wow!! The girls were starting to look a wee sad before, but now they're perking right up.

Another hurdle surmounted, and I don't believe we'll suffer from this issue any more. The NL's are finally starting to flower, when they get a little farther along more pics. Thanks to all out there following this thread, and looking forward to its successful conclusion.
:stylez rasta smoke:
Last edited:
Roark
Knight of the Scrog
- Joined
- Feb 23, 2013
- Messages
- 3,961
- Reputation
- 0
- Reaction score
- 10,712
- Points
- 0
- Currently Smoking
- Repel white widow and sour straws
Looking amazing! Way to go on catching that before it became death to those lovely ladies. That is one thing I'm envious of...the ability to pick your plants up and look at the rights. Mine just sit there in the table and collect gunk. I have started rinsing them through when I do a res change. That seems to help or atleast help me.
Looking amazing! Way to go on catching that before it became death to those lovely ladies. That is one thing I'm envious of...the ability to pick your plants up and look at the rights. Mine just sit there in the table and collect gunk. I have started rinsing them through when I do a res change. That seems to help or atleast help me.
Yeah, it is nice to have that ability. Rinsing on the regular sounds like a great idea for your setup. I know this tea is organic and I've heard that if you don't need to it's best not to introduce organics into a hydro system, but I haven't seen explosive root development like this and then I introduce the compost tea and 2 days later I am no less than shocked by the seeming fact that rather than slowing down while recovering from the algae the root growth seems ridiculously accelerated, and all the microorganisms in this tea are supposed to be excellent for root and plant development. The proof seems to be in the pudding on this one, it's up to the individual hydro grower to decide if it's right for their system, but I believe I'm sold on having the beneficials as a part of our regimen, probably will work it in at the beginning when starting rooted clones, along with a little fast start, and probably inoculate them again at the beginning of flower. Each time you use the tea you run it in your system for just 3-4 days at max, and then do a regular bucket change with regular nutrients and then re-apply the tea in 3-5 days if necessary (re-application should only be needed if currently fighting an algae problem not if just using as a preventative measure and root enhancer) sounds like you've gotten some really nice yields great job on your garden, and really cool you ended up with different types of smoke to sate the desires of everyone in the household. Looking forward to your final weigh in and more nugporn. Hope ours look as crystalline as your stuff
:stylez rasta smoke:
7/24/13: Got done with a couple days worth of work yesterday. Went and got a 32 gallon plastic trash can at Lowe's to use as my RO water reservoir:

got a dozen more net pots and several more buckets for the new clones we just got started, along with an air pump, splitters and stones, covered the growing medium on all of the bubble buckets with white posterboard to avoid further green algae growth, tied up some sagging buds on Marsha, built the mother/clone/seedling room and gotten it burning bright on an 18/6 schedule and we finally have done some ventilation work over in Marsha's room, one 340cfm fan intaking through a hepa filter into the air cooled tube (the dual spectrum bulb burned out and I replaced it with a 1000w HPS) with another fan placed on the floor sucking the intake air through and into the room,


no exhaust yet, but waiting to build one because all the windows in this area of the basement open into a neighbors yard, therefore, before exhausting I want to have a carbon filter attached since Marsha is in flower at the moment. Here's the new mother/clone/seedling room in all it's glory!


I accidentally put the mothers in with Marsha overnight (they got a 12 hr dark period) and both the Goji OG's sexed a day later, Both Female! Score!!


The Brooklyn Mango is doing great as well:

But the Sweet Deep Grapefruit is still rather small, though healthy looking:

Here's how the auto room is coming along,





the NL autos have a good week of flowering under their belts and the Rainbow Jones clones are doing great, another couple weeks and two of them will be flowering right alongside Marsha, also we just put roots in the res on six new clones, 3 Boss Hog and 3 Kandy Kush so we have stuff to continually push in the photoperiod flowering room (we'll select the best two of each) after the Rainbow Jones. By the time these plants all enter into flower room we'll be taking the first clones from our stock, and we'll probably start with one of the Goji's, as vigorous as they are proving to be. Finally Marsha's buds are well into week 5 and getting swollen, stinky and crystally! We have a 100x Pocket scope on the way and I'm excited to start scoping trichs! Here's some update pics:






Harvest time in another 4-5 weeks!!
Hop digity
:stylez rasta smoke:

got a dozen more net pots and several more buckets for the new clones we just got started, along with an air pump, splitters and stones, covered the growing medium on all of the bubble buckets with white posterboard to avoid further green algae growth, tied up some sagging buds on Marsha, built the mother/clone/seedling room and gotten it burning bright on an 18/6 schedule and we finally have done some ventilation work over in Marsha's room, one 340cfm fan intaking through a hepa filter into the air cooled tube (the dual spectrum bulb burned out and I replaced it with a 1000w HPS) with another fan placed on the floor sucking the intake air through and into the room,


no exhaust yet, but waiting to build one because all the windows in this area of the basement open into a neighbors yard, therefore, before exhausting I want to have a carbon filter attached since Marsha is in flower at the moment. Here's the new mother/clone/seedling room in all it's glory!


I accidentally put the mothers in with Marsha overnight (they got a 12 hr dark period) and both the Goji OG's sexed a day later, Both Female! Score!!


The Brooklyn Mango is doing great as well:

But the Sweet Deep Grapefruit is still rather small, though healthy looking:

Here's how the auto room is coming along,





the NL autos have a good week of flowering under their belts and the Rainbow Jones clones are doing great, another couple weeks and two of them will be flowering right alongside Marsha, also we just put roots in the res on six new clones, 3 Boss Hog and 3 Kandy Kush so we have stuff to continually push in the photoperiod flowering room (we'll select the best two of each) after the Rainbow Jones. By the time these plants all enter into flower room we'll be taking the first clones from our stock, and we'll probably start with one of the Goji's, as vigorous as they are proving to be. Finally Marsha's buds are well into week 5 and getting swollen, stinky and crystally! We have a 100x Pocket scope on the way and I'm excited to start scoping trichs! Here's some update pics:

Harvest time in another 4-5 weeks!!
Hop digity
:stylez rasta smoke:
Last edited:
Wow! Great. Great Growing. Great Garden...Go! Go! Go!
Similar threads
- Replies
- 2
- Views
- 280
- Replies
- 5
- Views
- 759
- Replies
- 0
- Views
- 93
